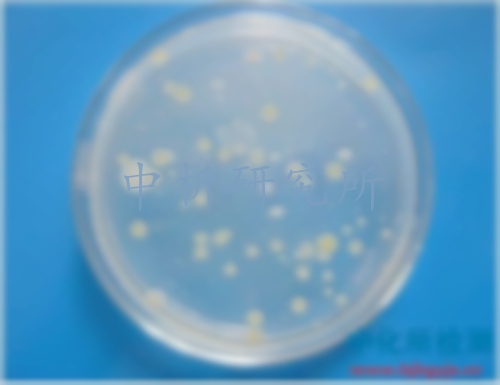

糞大腸菌群檢測
1對1客服專屬服務,免費制定檢測方案,15分鐘極速響應
發布時間:2025-07-25 08:49:03 更新時間:2025-09-14 14:37:04
點擊:2319
作者:中科光析科學技術研究所檢測中心
1對1客服專屬服務,免費制定檢測方案,15分鐘極速響應
發布時間:2025-07-25 08:49:03 更新時間:2025-09-14 14:37:04
點擊:2319
作者:中科光析科學技術研究所檢測中心
糞大腸菌群檢測去哪里做?大腸菌群是評價食品衛生質量的重要指標之一,中析研究所檢測中心可對各類樣品的糞大腸菌群進行檢測。
醫療廢水,土壤,垃圾滲濾液,城市生活污水,地表水,化妝品,污泥,飲用水,肥料、養殖場糞污水,地表水、牙膏。
1GB 4789.39-2013食品安家標準 食品微生物學檢驗 糞大腸菌群計數
2GB/T 7918.3-1987化妝品微生物標準檢驗方法 糞大腸菌群
3GB/T 19524.1-2004肥料中糞大腸菌群的測定
4HJ 347.1-2018水質 糞大腸菌群的測定 濾膜法
5HJ 347.2-2018水質 糞大腸菌群的測定 多管發酵法
6HJ 755-2015水質 總大腸菌群和糞大腸菌群的測定 紙片快速法
7HJ 1001-2018水質 總大腸菌群、糞大腸菌群和大腸埃希氏菌的測定 酶底物法
8JC/T 542-2010滑石粉微生物學檢驗方法
9NY/T 555-2002動物產品中大腸菌群、糞大腸菌群和大腸桿菌的檢測方法
10SL 355-2006水質 糞大腸菌群的測定多管發酵法
11SN/T 0169-2010進出口食品中大腸菌群、糞大腸菌群和大腸桿菌檢測方法
12SN/T 1607-2017出口飲料中菌落總數、大腸菌群、糞大腸菌群、大腸桿菌技術方法 疏水柵格濾膜法
13SN/T 3924-2014出口貝類中大腸菌群、糞大腸菌群檢測方法
1、中析研究所糞大腸菌群檢測中心資質齊全,資質認證的第三方檢測機構。
2、數據準確,博士團隊,歐美進口檢測設備,保證了數據的準確性。
3、研究所檢測報告支持二維碼查詢真偽。
4,多家分支機構,支持上門取樣,免費初檢。
5,售后服務,相關工程師一對一服務。
6,可出具中英文檢測報告,及msds報告編寫服務。
1、電話咨詢
2、郵寄糞大腸菌群樣品或上門取樣。
3、工程師報價
4、支付檢測費用,開展實驗。
5、完成實驗,出具檢測報告。
6、郵寄檢測報告,售后服務。
證書編號:241520345370
證書編號:CNAS L22006
證書編號:ISO9001-2024001

版權所有:北京中科光析科學技術研究所京ICP備15067471號-33免責聲明